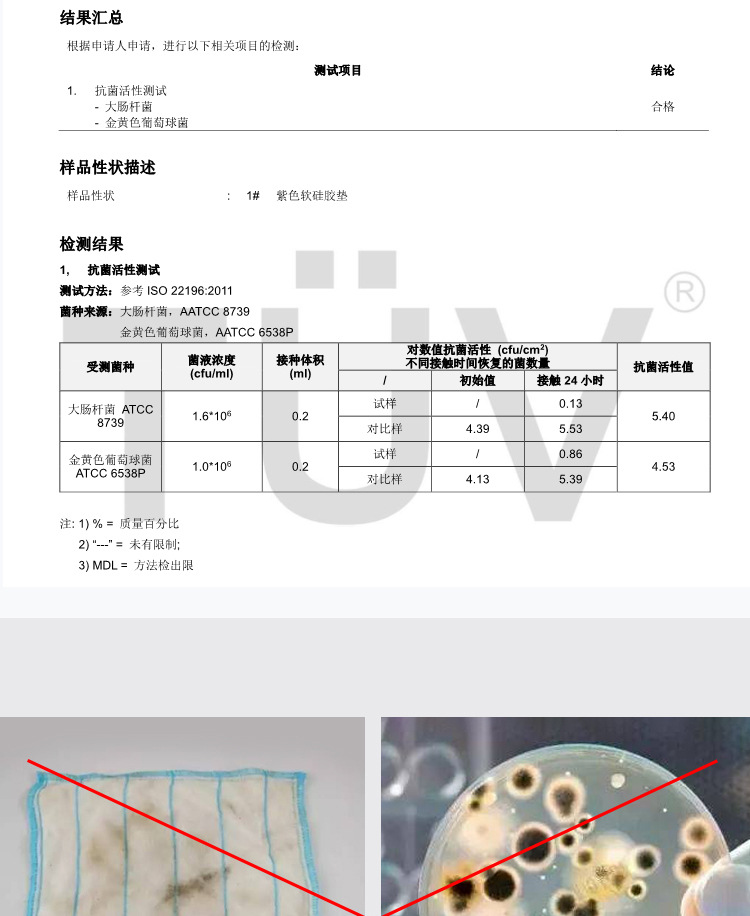
抗菌垫_03.jpg

Search history
Clear allSearch by image
XDrag and drop an image here or upload an image
Max 5MB per image
UploadSign In | Join
X Email Mobile
| pink: 30*30 (solid bottom) | ¥17.64 | 4774 piece available |
|
| dark gray: 40*30 (solid bottom) | ¥19.11 | 4462 piece available |
|
| purple: 30*30 (solid bottom) | ¥17.64 | 4407 piece available |
|
| dark gray: 30*30 (solid bottom) | ¥17.64 | 4773 piece available |
|
| water blue: 30*30 (solid bottom) | ¥17.64 | 4674 piece available |
|
| water blue: 40*30 (solid bottom) | ¥19.11 | 4655 piece available |
|
| pink: 40*30 (solid bottom) | ¥19.11 | 4464 piece available |
|
| white and gray: 30*30 (solid bottom) | ¥17.64 | 4669 piece available |
|
| purple: 40*30 (solid bottom) | ¥19.11 | 4919 piece available |
|
| white and gray: 40*30 (solid bottom) | ¥19.11 | 4664 piece available |
|
A new item has been added to your Shopping Cart. You now have items in your Shopping Cart.
Yiwu Yijia Daily Necessities Firm 14yr.
Contacts:zhangyundeChat
Mobile:86-13777912375
E-mail:1714665791@qq.com

Update time:
TOP